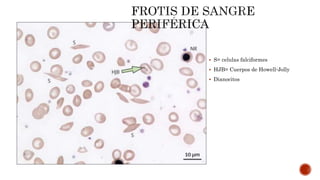
 S= celulas falciformes
 HJB= Cuerpos de Howell-Jolly
 Dianocitos

Este documento describe la anemia falciforme, el trastorno genético más común en el mundo. Se debe a una mutación en el gen de la beta-globina que causa la formación de hemoglobina S rígida. Esto conduce a la destrucción de los eritrocitos y oclusión vascular, causando síntomas como dolor, infecciones y daño orgánico. El tratamiento incluye hidroxiurea, transfusiones de sangre y quelación de hierro, aunque el trasplante de médula ósea es el único curativo. Se necesita